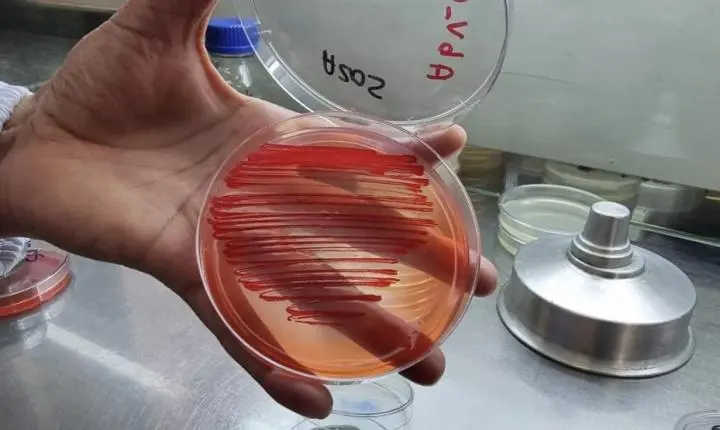
Bactérias aumentam produtividade em lavouras de arroz, feijão e milho

Espaço para comunicar erros nesta postagem
Uma série de pesquisas realizadas pela Embrapa com diferentes rizobactérias (atuantes na raiz) demonstrou que alguns microrganismos podem ser importantes aliados da agricultura. Eles atuam melhorando os processos fisiológicos da planta, promovendo melhor absorção de nutrientes ou facilitando a sua disponibilização.
O resultado são plantas maiores, mais resistentes a doenças e com maior produtividade. Com fertilizantes importados cada vez mais caros, o uso desses insumos biológicos pode representar uma importante economia ao produtor. Os experimentos comprovaram ganhos importantes em lavouras de arroz, feijão, milho e soja.
Efeito das bactérias sobre o arroz
Em uma pesquisa realizada pela Embrapa Arroz e Feijão, foi medido o efeito de bactérias que habitam o solo sobre plantas de arroz de terras altas. O trabalho se valeu do conhecimento prévio acerca de seis tipos de microrganismos que reconhecidamente promovem benefícios para as culturas agrícolas, porém ainda pouco estudados com o cereal.
No laboratório, para cada uma dessas bactérias selecionadas, foi feita uma solução aplicada a sementes de arroz em um processo chamado microbiolização. Em meio de cultivo em tubos de ensaios, houve o desenvolvimento de mudas que, ao serem analisadas com o auxílio de equipamentos de processamento e programas de avaliação de imagens, apontaram um resultado promissor como o maior arranque inicial e melhor desenvolvimento radicular das plântulas.
A Bactéria Azospirillum
Nos testes, as raízes das mudas de arroz tratadas com um tipo de bactéria chamada Azospirillum foram 86% mais longas que o tratamento controle, que não recebeu nenhum microrganismo. Além disso, houve ainda, comparativamente, um incremento de mais de 100% no volume de raízes.
De acordo com um dos coordenadores o estudo, o pesquisador da Embrapa Adriano Nascente, isso pode representar maior capacidade para a planta em absorver nutrientes do solo, o que pode impactar positivamente a produtividade.
Outro trabalho coordenado por Nascente e semelhante ao realizado com o arroz de terras altas foi conduzido com a cultura do milho e teve resultados parecidos, feitos também em ambiente de cultivo controlado.
O microrganismo Azospirillum proporcionou maiores valores em comprimento, diâmetro, volume e massa seca das raízes, além da massa seca de parte aérea e massa seca total em comparação ao tratamento controle (sem a bactéria).
Além de Azospirillum, o cientista conta ainda que já foi comprovado em ambiente de laboratório que outras rizobactérias do tipo Bacillus, Burkholderia e Serratia são capazes de gerar maior desenvolvimento de raízes em plantas de soja, arroz e milho (veja estudo).
Esses microrganismos proporcionaram entre 24% e 31% de aumento do comprimento de raízes em plantas de arroz irrigado por inundação.
Do laboratório para o campo
O avanço em etapas de pesquisa, com a condução de trabalhos inicialmente realizados em laboratório para situações de campo, é importante também para entender melhor como funcionam mecanismos biológicos complexos de interação, aliados a práticas de manejo das lavouras.
Em outro trabalho, a equipe de Nascente avaliou combinações de Serratia, um gênero de bactéria, com diferentes doses de nitrogênio, fósforo e potássio (NPK) em áreas experimentais de arroz de terras altas, na Fazenda Capivara, pertencente à Embrapa e localizada em Santo Antônio de Goiás (GO).
O objetivo foi maximizar o efeito desses macronutrientes, por meio de sua associação com o microrganismo.
O objetivo foi maximizar o efeito desses macronutrientes
Nesse caso, as sementes também passaram pelo procedimento de microbiolização antes da semeadura e, aos sete e aos quinze dias após o plantio, o solo recebeu pulverizações com a mistura líquida previamente preparada em laboratório com Serratia.
O resultado de três colheitas foi um aumento médio de produtividade em 17% (cerca de 630 quilos por hectare a mais, considerando a produção total de 3.700 quilos por hectare ou 61 sacos de arroz) nos locais em que a bactéria estava presente, em comparação com a área que não possuía o tratamento com o microrganismo.
Já o aumento médio na produtividade de grãos para cada macronutriente combinado à bactéria Serratia foi de 16% para potássio, 17% para nitrogênio e 23% para fósforo. Em relação a este último elemento, ocorreu um fato importante que chamou a atenção dos pesquisadores.
Não existiu diferença no rendimento de grãos para os tratamentos de Serratia com e sem fertilizantes fosfatados. Isso sugere um benefício proporcionado pelo microrganismo.
A bactéria Serratia
A pesquisadora Marta Cristina Corsi de Filippi, que participou desse estudo, explicou essa evidência.
“A bactéria Serratia secreta ácidos orgânicos e enzimas capazes de transformar o fósforo já presente no solo em formas solúveis e capazes de serem absorvidas pelas raízes das plantas de arroz. Assim, podemos considerar que os teores de fósforo que existiam na área antes do plantio, devido a adubações anteriores, porém indisponíveis para as plantas, igualavam-se a um estoque que foi disponibilizado para a lavoura quando houve a atividade biológica da bactéria Serratia”, detalha a cientista.
Conforme a pesquisadora, as perspectivas são muito positivas, pois esse estudo com Serratia pode originar um produto comercial.
“Estamos trabalhando em parceria com o setor privado. Como fruto desta parceria, teremos um produto comercial, que levará junto indicadores de qualidade para a produção no sistema on farm. Os resultados obtidos com aplicação desse microrganismo, desde os ensaios preliminares de laboratório, até os testes em campo, com parcelas maiores, nos revelaram que, além de melhorar o estado nutricional da planta, houve também melhoria da sanidade. As plantas se tornaram mais saudáveis, desde a raiz até a parte aérea. As plantas de arroz tratadas com Serratia apresentaram até 60% menos doenças, como mancha parda, queima da bainha e brusone, a doença mais prejudicial ao arroz”, relata.
Combinação entre fungo e bactéria
Além do uso combinado entre Serratia e fertilizantes NPK, essa bactéria também vem sendo estudada pela pesquisa em mistura com um fungo bastante aplicado na agricultura, o Trichoderma.
Em experimentos de campo na Embrapa, uma solução aquosa com Serratia e Trichoderma foi pulverizada no sulco durante o processo de semeadura do feijão.
A utilização desses microrganismos gerou 17% de aumento na produtividade de grãos, em relação ao tratamento sem a aplicação da mistura.
A hipótese destacada é que esse resultado pode ter ocorrido por causa da capacidade desses microrganismos de proporcionar incrementos no desenvolvimento das plantas pela absorção de nutrientes, produção de hormônios de crescimento e estímulo à maior eficiência de mecanismos de fotossíntese.
Segundo Nascente, outros estudos similares combinando, em pares, diferentes rizobactérias do tipo Bacillus, Burkholderia, Serratia e Azospirillum, assim como o fungo Trichoderma caminham nessa mesma direção e permitem afirmar que esses microrganismos são uma boa estratégia para incrementar o rendimento de grãos de feijão.
Controle de qualidade necessário
O estudo com microrganismos em associação a plantas pode gerar produtos comerciais, bastando comprá-los e aplicá-los nas lavouras; ou ainda podem ser adquiridos os agentes biológicos para a produção do bioinsumo dentro da própria fazenda (on farm).
Em ambos os casos, trata-se de uma prática que requer a observação de critérios de qualidade.
De acordo com o analista em microbiologia e bioinsumos da Embrapa Marcio Vinicius Côrtes, o controle de qualidade é uma atividade importante.
“Trata-se de uma das etapas imprescindíveis na produção dos bioinsumos, independentemente do modelo de produção utilizado. A qualidade do bioproduto está atrelada à sua eficiência no campo. A concentração adequada de células microbianas e a pureza do bioinsumo, ou seja, ausência de microrganismos contaminantes, são fatores-chave para que o produto alcance o seu efeito esperado”, ressalta.
A produção dos bioinsumos envolve investimentos em infraestrutura e em acompanhamento de profissionais capazes de zelar pela qualidade dos procedimentos de fabricação.
Processo de produção de bioinsumos
O especialista frisa que todas as etapas do processo de produção de bioinsumos contêm pontos críticos, desde a recepção da matéria-prima até o estoque do produto final, formulado e envasado ou não.
Ele ainda ressalta que a utilização de uma estirpe ou cepa autêntica e reconhecidamente eficiente é outra condição mínima para o sucesso dessa prática.
“Somado aos investimentos em equipamentos e adequação das estruturas prediais da planta de produção, é necessário que a equipe envolvida nos processos desenvolvam protocolos, faça registros e realize acompanhamento constante das diversas etapas relacionadas, tomando ações preventivas e corretivas, quando necessário, dentro do contexto das Boas Práticas de Fabricação”, recomenda Côrtes.
De acordo com Côrtes, a não observação de procedimentos de qualidade pode gerar danos à produtividade, ao trabalhador rural e ao consumidor.
Controle mínimo do processo de fermentação
A produção de microrganismos em meio de cultivo líquido em recipientes inapropriados como caixas d ‘água, que não permitem o controle mínimo do processo de fermentação, é um clássico exemplo negativo.
“A produção inadequada dos bioinsumos resultará em um produto de baixa qualidade, que por sua vez não apresentará o efeito esperado no manejo, podendo levar essa excelente tecnologia ao descrédito. Ainda vale ressaltar que um processo de produção mal conduzido pode resultar na multiplicação de microrganismos patogênicos a humanos, ou seja, pode acarretar doenças. É importante mencionar que um bioproduto decorrente de um processo de produção bem conduzido, será seguro não só para o agricultor, mas também para o consumidor final”, completa.
Nossas notícias
no celular

JL Notícias
JL Notícias 
